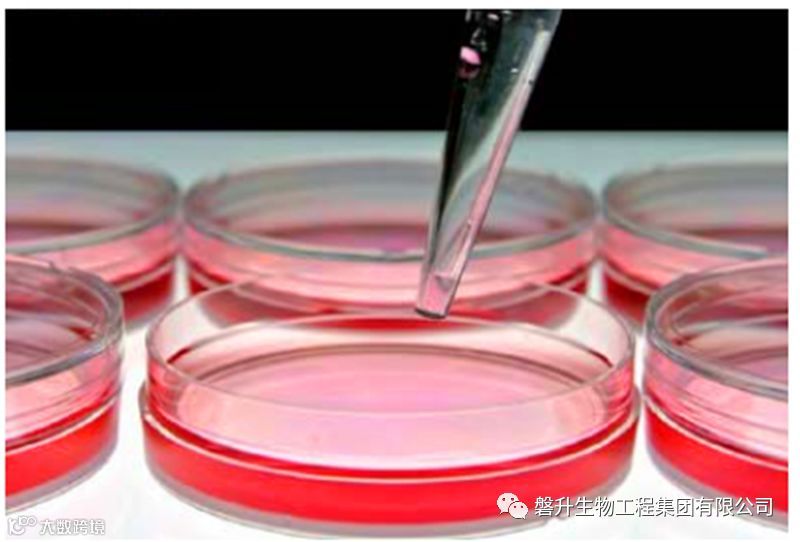

而当五花八门的“胶原蛋白”产品,诸如“胶原蛋白口服液”、“胶原蛋白分子肽”、“胶原蛋白美容针”等等充斥市场,胶原蛋白从被炒的火热到再被贬的一文不值,目前人们对于胶原蛋白的评价充满了两极分化:有些人奉若神明,有些人嗤之以鼻,有的人喊打喊杀,但是喊打喊杀的人里面又有些人其实欲罢不能。那么,胶原蛋白究竟是什么呢?胶原蛋白到底有什么样的功效及应用,今天磐升生物给大家来一次走心的科谱,希望大家理性地对待胶原蛋白。

胶原蛋白为人体主要的细胞外间质成分之一,是人体蛋白质的一大家族。
胶原蛋白是生物高分子,动物结缔组织中的主要成分,也是哺乳动物体内含量最多、分布最广的功能性蛋白,占蛋白质总量的25%~30%,某些生物体甚至高达80%以上。
目前已发现有27种不同类型的胶原蛋白,常见类型为Ⅰ型、Ⅱ型、Ⅲ型、Ⅴ型和Ⅺ型。

胶原蛋白是构成动物机体的重要功能物质,它具有其他合成高分子材料无法比拟的生物相容性和生物可降解性。胶原蛋白质结构和功能特点的多样性和复杂性,决定了其在许多领域的重要地位,以及良好的应用前景。
目前主要在食品、医药、组织工程、化妆品等领域获得广泛的应用。

磐升生物就是采用这种I型胶原蛋白作为人工皮肤的支架材料,应用组织工程学的方法,将种子细胞与支架材料相结合,体外构建具有表皮与真皮的双层活性皮肤,将其种植于创面,促进细胞生长、分化,调控创面微环境,支架材料逐渐吸收,达到修复创面,重建皮肤功能的目的。

营养性:胶原蛋白进可进入皮肤深层,给予皮肤所必需的营养成分(氨基酸),维持胶原纤维结构的稳定性和完整性。
保湿性:胶原蛋白含量有大量的甘氨酸、羟脯氨酸、羟基和羧基等亲水基团,提高皮肤的贮水能力。
修复性:胶原蛋白与皮肤中的胶原结构相似,所以具有优良的生物学特性,能促进上皮细胞的增生修复。补充所需的氨基酸,使受损老化的皮肤得到填充和修复。
亲和性:胶原蛋白的生物相容性好,与皮肤及头皮表面的蛋白质分子有较强的亲和力,主要通过物理吸附与皮肤和头发结合。

配伍性:胶原蛋白与其他化妆品成分混合时,可以起到调节PH、稳定PH及泡沫、乳化胶体等作用。还可减轻各种酸、碱、表面活性剂等刺激性物质对皮肤和毛发的损害。
抗皱:胶原蛋白与皮肤角质层结构的相似性决定它与皮肤良好的相容性、良好亲和力和渗透性,能渗透人皮肤表皮层,提高皮肤密度,产生张力。
美白:胶原蛋白中的酪氨酸残基与皮肤中的酪氨酸竞争,与酪氨酸酶的活性中心结合,从而抑制酪氨酸酶催化皮肤中的酪氨酸转化为多巴,阻止皮肤中的黑色素形成,达到美白作用。

磐升生物采用国内先进的低温连续提取纯化系统,确保胶原全程提取、纯化工艺在2-8℃的低温条件下进行,保证胶原的生物活性。胶原蛋白生产车间及整个生产过程通过了严格的医疗器械质量体系考核,从取材至胶原蛋白成品产出,采取一系列质量控制措施,严格把控,保证胶原蛋白的安全性和胶原蛋白的稳定性。